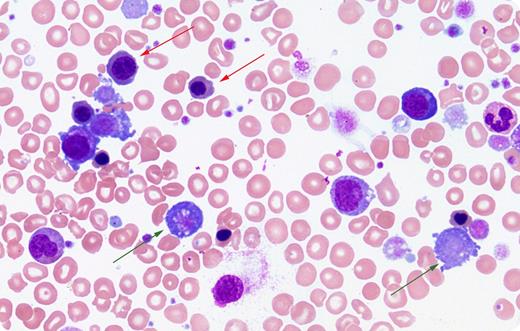
A 69-year-old woman was admitted with rapidly declining hypotension and respiratory failure requiring intubation. She had been diagnosed with polycythemia vera, JAK-2 (V617F) positive, 28 years earlier. After 20 years of stable disease she developed massive splenomegaly and progressed to myelofibrosis. Splenectomy had been performed 7 years earlier for symptomatic relief. Two weeks prior to admission, her hemoglobin was 114 g/L, leukocytes were 9.7 × 109/L, and platelets were 352 × 109/L. At admission, her complete blood count was reported with a leukocyte count of 133 × 109/L, although this was flagged as the impedance volume histogram of the leukocyte population produced by the cell counter had several abnormal peaks. Blood film showed a leukoerythroblastosis with numerous nucleated red blood cells (red arrows) and megakaryocytic fragments (green arrows). These cells were incorrectly identified as leukocytes by the cell counter, and manual examination of the peripheral smear revealed the leukocyte count was actually 41 × 109/L, although markedly left-shifted. The patient unfortunately died of cardiogenic shock and sepsis after care was withdrawn. / The blood film in this case confirmed an error in our automated cell counter and provided a window into her disease and perhaps into the stress placed onto her marrow.

A 69-year-old woman was admitted with rapidly declining hypotension and respiratory failure requiring intubation. She had been diagnosed with polycythemia vera, JAK-2 (V617F) positive, 28 years earlier. After 20 years of stable disease she developed massive splenomegaly and progressed to myelofibrosis. Splenectomy had been performed 7 years earlier for symptomatic relief. Two weeks prior to admission, her hemoglobin was 114 g/L, leukocytes were 9.7 × 109/L, and platelets were 352 × 109/L. At admission, her complete blood count was reported with a leukocyte count of 133 × 109/L, although this was flagged as the impedance volume histogram of the leukocyte population produced by the cell counter had several abnormal peaks. Blood film showed a leukoerythroblastosis with numerous nucleated red blood cells (red arrows) and megakaryocytic fragments (green arrows). These cells were incorrectly identified as leukocytes by the cell counter, and manual examination of the peripheral smear revealed the leukocyte count was actually 41 × 109/L, although markedly left-shifted. The patient unfortunately died of cardiogenic shock and sepsis after care was withdrawn.
The blood film in this case confirmed an error in our automated cell counter and provided a window into her disease and perhaps into the stress placed onto her marrow.
A 69-year-old woman was admitted with rapidly declining hypotension and respiratory failure requiring intubation. She had been diagnosed with polycythemia vera, JAK-2 (V617F) positive, 28 years earlier. After 20 years of stable disease she developed massive splenomegaly and progressed to myelofibrosis. Splenectomy had been performed 7 years earlier for symptomatic relief. Two weeks prior to admission, her hemoglobin was 114 g/L, leukocytes were 9.7 × 109/L, and platelets were 352 × 109/L. At admission, her complete blood count was reported with a leukocyte count of 133 × 109/L, although this was flagged as the impedance volume histogram of the leukocyte population produced by the cell counter had several abnormal peaks. Blood film showed a leukoerythroblastosis with numerous nucleated red blood cells (red arrows) and megakaryocytic fragments (green arrows). These cells were incorrectly identified as leukocytes by the cell counter, and manual examination of the peripheral smear revealed the leukocyte count was actually 41 × 109/L, although markedly left-shifted. The patient unfortunately died of cardiogenic shock and sepsis after care was withdrawn.
The blood film in this case confirmed an error in our automated cell counter and provided a window into her disease and perhaps into the stress placed onto her marrow.
For additional images, visit the ASH IMAGE BANK, a reference and teaching tool that is continually updated with new atlas and case study images. For more information visit http://imagebank.hematology.org.
This feature is available to Subscribers Only
Sign In or Create an Account Close Modal